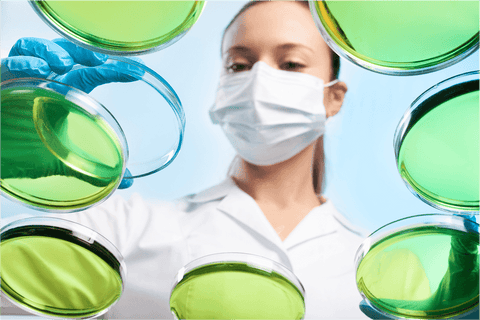

What is the Difference Between Berberine Advanced and Berberine Phytosome?
Key Takeaways
-
Berberine Phytosome absorbs better: It helps your body use berberine more effectively for stronger results.
-
Supports blood sugar and heart health: Helps balance glucose, lower cholesterol, and boost metabolism.
-
Works faster with fewer side effects: Better absorption means quicker benefits and less stomach discomfort.
Understanding Berberine and Berberine Phytosome
Berberine has been used in traditional medicine for centuries, but modern supplement technology has led to improved forms like Berberine Phytosome. This section explains what Berberine is and how Berberine Phytosome works to enhance absorption and health benefits.
What is Berberine?
Berberine is a natural plant compound found in herbs like Berberis aristata. It has been used for centuries in traditional medicine to support blood sugar control, cholesterol levels, and gut health. However, regular Berberine has poor absorption, meaning your body struggles to use it effectively.
What is Berberine Phytosome and How Does It Work?
This enhanced form of berberine is designed for better absorption. It is combined with phospholipids, which help increase absorption in the body. This means you can get better results with a lower dose, making it more efficient than standard Berberine.
Key Differences Between Berberine Advanced and Berberine Phytosome
While both Berberine Advanced and Berberine Phytosome offer health benefits, their effectiveness depends on absorption, bioavailability, and overall impact on the body. This section highlights the primary distinctions between the two.
Absorption and Bioavailability
One of the biggest challenges with standard Berberine is its low bioavailability—only a small percentage gets absorbed. Berberine Phytosome solves this issue by using a phospholipid delivery system, which helps it pass through cell membranes more easily.
Health Benefits and Effectiveness
While both forms support metabolic health, the Berberine Phytosome is designed for faster and more efficient results. Studies suggest that it:
-
Improves insulin sensitivity better than standard Berberine.
-
Lowers LDL cholesterol and supports heart health more effectively.
-
Enhances gut health by promoting a balanced microbiome.
Safety Profile and Potential Side Effects
Both forms are safe for most people. Some may experience mild digestive issues like bloating or nausea, but this improved formula may ease stomach discomfort due to better absorption.
Clinically Studied Benefits of Berberine Phytosome
Studies confirm that this advanced berberine formulation absorbs better and works more efficiently. This section reviews some of the key clinically studied benefits.
Superior Bioavailability for Enhanced Absorption
Scientific research shows that Berberine Phytosome has up to 5 times better absorption than standard Berberine, allowing for lower doses with greater impact.
Blood Sugar and Lipid Metabolism Support
This phospholipid-bound berberine supports blood sugar balance and is widely used for metabolic health. It also assists in reducing triglycerides and LDL cholesterol.
Cardiovascular and Metabolic Health Advantages
With better absorption and higher potency, Berberine Phytosome may provide stronger support for heart health and weight management.
Order your Berberine Advanced today and support your wellness journey.
Comparing Berberine Phytosome and Berberine HCl
Standard Berberine HCl has been widely used, but how does it compare to the advanced Berberine Phytosome? This section breaks down their key differences in effectiveness and usage.
How Bioavailability Impacts Effectiveness
Standard Berberine HCl is poorly absorbed and often requires high doses to see results. Berberine Phytosome offers superior absorption, meaning your body can use it more effectively at lower doses.
Differences in Usage and Health Applications
-
Berberine HCl: Works but requires higher doses to be effective.
-
Berberine Phytosome: Provides better results with lower doses due to enhanced absorption.
Which One is Better for Long-Term Health Goals?
If you're looking for fast, consistent results, Berberine Phytosome is likely the better choice. Its improved bioavailability makes it more effective over time compared to Berberine HCl.
Choosing the Right Berberine Supplement for Your Needs
Deciding between Berberine Advanced and this optimized formula depends on your dosage needs, health goals, and absorption preferences.
Dosage Recommendations and Supplement Stacking
-
Berberine HCl: Typical doses range from 900-1500mg per day.
-
Berberine Phytosome: Requires a lower dose (about 300-600mg per day) due to better absorption.
-
Stacking: Can be taken with NMN, Resveratrol, or Magnesium for added benefits.
Suitability for Different Health Conditions
-
For blood sugar control: Berberine Phytosome is often preferred due to better absorption.
-
For cholesterol support: Both work, but the Berberine Phytosome may act faster.
-
For digestive health: Some people find Berberine Phytosome gentler on the stomach.
How Long to Take Berberine Phytosome for Optimal Results
For best results, take Berberine Phytosome consistently for 8-12 weeks, adjusting as needed.
FAQs
Does berberine reduce belly fat?
Yes, berberine may help burn belly fat by improving insulin levels, boosting metabolism, and breaking down fat. It works best with a healthy diet and exercise.
How quickly do you lose weight with berberine?
Results vary, but many people see changes in 4 to 12 weeks. Berberine helps control blood sugar and speed up metabolism, leading to steady weight loss.
Is berberine hard on the kidneys?
Berberine is safe for healthy kidneys when taken as directed. If you have kidney disease, check with your doctor before using it.
Can berberine cause hair loss?
No, berberine does not cause hair loss. It may even help by reducing inflammation and balancing blood sugar, which supports healthy hair growth.
How long is it OK to take berberine?
It’s safe to take for months at a time. Many people use it for 8-12 weeks, then take a short break before starting again.
Conclusion
Berberine Phytosome works better than regular berberine because your body absorbs it more easily. This means stronger support for blood sugar, heart health, and metabolism. If you want a more effective berberine supplement, Berberine Phytosome is a great choice. Ready to try it? Check out Just Glow for high-quality supplements today!
Summary
Is regular berberine hard to absorb? Berberine Phytosome fixes this with better absorption, helping your body use it more effectively for blood sugar and heart health. But how is it different from Berberine Advanced or Berberine HCl? This guide explains the key differences, benefits, and which one may be best for you. Let’s get started!